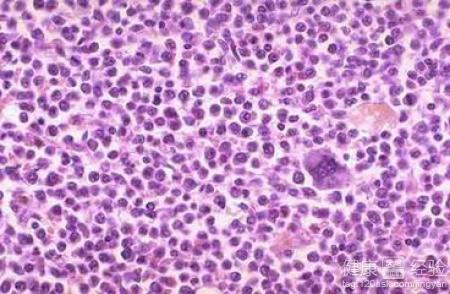
請問吃什麼食物可以降低血脂?

高血脂是現在很多中老年人都會患的疾病,得高血脂的原因有很多種,治療的方法也很多,那麼要說最健康的就莫過於通過運動來降低血脂了。現在是吃的好,喝的好,所以大部分都有高血脂、高血壓、高血糖三高病,我也是,因為平時應酬導致的高血脂,為此我專門咨詢了營養師,他給了我六種食物讓我堅持吃。下面我就把著六種食物給大家介紹下。
1一般來說,患有高血脂症而無其它合並症者應保持中等強度運動量,即每天達到慢跑3至5公裡的運動量。對有輕度高血壓、肥胖等並發疾病的患者應自行掌握,以鍛煉時不發生明顯的身體不適為原則。
2平時的時候也可以多吃點韭菜,韭菜裡面最重要的就是含有胡蘿卜素和大量纖維素,它們都能夠增強胃腸蠕動有很好的通便作用,能幫助排除腸道中多余的脂肪。,大蒜減少血液中膽固醇和防止血栓形成,有助於增加高密度膽固醇,對減肥有利。

3咖啡因會增加體內的膽固醇,因此,應注意盡量少喝咖啡、茶,並禁服含有咖啡因的藥物。堅持每頓飯“七分飽”的原則,堅持少吃多餐;要保持每天大便通暢,控制粗糧等高纖維食物的食用比例。
少吃動物內髒、肥肉等,還應合理調劑飲食結構,如晚餐不宜多食油膩的食物;少吃甜食,以免血液中的甘油三酯升高,血液黏稠度增加,促使病變加快。
Copyright © 天天健康網 All Rights Reserved